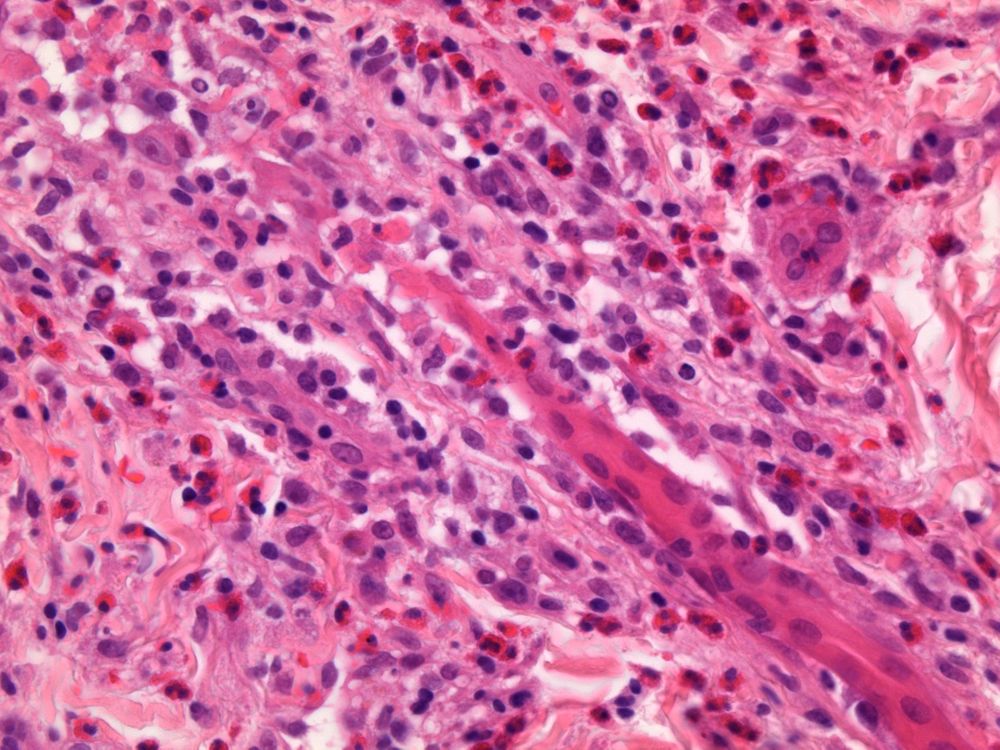

x4 more H&E.
23.01.2025 07:29 — 👍 3 🔁 1 💬 0 📌 0@histopatolomon.bsky.social
Patólogo General #pathologist #pathology Interés en todo lo relacionado con la patología y además, los cuerpos extraños en medicina y la histología comparada de animales y plantas. https://www.flickr.com/photos/foreignbodies/

x4 more H&E.
23.01.2025 07:29 — 👍 3 🔁 1 💬 0 📌 0



2025 Wk3 RAC3372. M18. Widespread oedematous erythematous rash. One from the archives. I'll post x4 and additional x4. Differential Diagnosis? #Dermpath
23.01.2025 07:26 — 👍 4 🔁 2 💬 5 📌 0
Birda app says this:
08.12.2024 16:36 — 👍 5 🔁 2 💬 0 📌 0

Walking along the ocean beach this morning came across the shorebirds. Anyone can identify? #birds
08.12.2024 15:56 — 👍 9 🔁 2 💬 2 📌 0So sad 😒
08.12.2024 16:48 — 👍 0 🔁 0 💬 0 📌 0
Added to #FBAtlas thanks for your contribution www.flickr.com/photos/forei...
08.12.2024 11:39 — 👍 1 🔁 0 💬 1 📌 01+
06.12.2024 11:34 — 👍 1 🔁 0 💬 0 📌 0


Cytokeratin 7 immunohistochemical stain
Chromophobe renal cell carcinoma (ChRCC), kidney, H&Es, 20x and 40x, CK7, 20x: Plant-like tumor cells - Vimentin negative; CK7 and C-Kit positive!
#pathology #pathsky #surgicalpathology #renalpathology #renalcellcarcinoma #renalpathology #RCC #kidneypathology #ChRCC #pathart


Monotonous oval to spindle cells with minimal cytologic atypia, often demonstrating whorling around blood vessels

LVI

H&E, CD10, ER, PR
Low-Grade Endometrial Stromal Sarcoma (LG-ESS), uterus: Proliferative-phase endometrial stromal-type tumor cells with “tongue/finger-like pattern” of myometrial invasion, frequent LVI - CD10, IFITM1 & ER/PR positive!
#pathology #pathsky #gynpath #oncsky #sarcoma #lgess #surgicalpathology #pathart

The #NephSIM Urine Gallery
nephsim.com/urine-gallery/
#UrineMicroscopy #SpinUrine #FOAMed 💛
Since Swifties have moved en masse, I’d like to re-present one of my favorite threads 😍
Inspired by beautiful #urinemicroscopy pictures posted elsewhere... I present to you
⭐️Taylor Swift as #urinarysediment 🔬⭐️ findings...
1/ Bilirubin pigmented RTEC (renal epithelial cell cast)
🧵 #NephSky #MedSky


And here an example of the classic rhomboid shape
04.12.2024 13:37 — 👍 4 🔁 1 💬 0 📌 0
Hola Juan Carlos, ¿das tu permiso para incorporar estas fotos al atlas de cuerpos extraños en medicina, con sus correspondientes créditos? #foreignbodies
www.flickr.com/photos/forei...
🤩
06.12.2024 10:57 — 👍 1 🔁 0 💬 0 📌 0


Calcium oxalate monohydrate crystals - brightfield, darkfield, and polarized - from a pt with acute ethylene glycol poisoning - #UrineMicroscopy #UrinarySediment
14.11.2024 01:52 — 👍 20 🔁 9 💬 0 📌 1Triple phosphate (Struvite) crystals in a “sea” of bacteria (Proteus sp). #UrinarySediment #UrineMicroscopy #PisseProphet
16.11.2024 16:51 — 👍 15 🔁 3 💬 1 📌 0



One of many shapes of urinary uric acid crystal, a dihydrate form. Contaminating fiber over it. #UrinarySediment #Crystalluria #UrineMicroscopy
04.12.2024 13:35 — 👍 13 🔁 4 💬 5 📌 0
Tubular epithelial cell cast - brightfield with SM stain - from new consult: admitted with SOB, nodular pulm infiltrate, and AKI - serologies pending. bx today ... #UrineMicroscopy #UrinarySediment
04.12.2024 00:59 — 👍 5 🔁 3 💬 0 📌 0



6/n so, we applied the PB stain and this is what we found: clear evidence of WBC casts, mixed with some granular, and other RTEC casts too. Were they missed earlier? Hard to say, but they were visible on this day. Steroids were started.
04.12.2024 23:22 — 👍 9 🔁 2 💬 1 📌 0

5/n so we pull the Prescott-Brodie stain out of the shelf. Stain revived by Ralph Mohty @rmohty.bsky.social Only WBCs are expected to stain blue, like in the images below. See this technical paper watermark.silverchair.com/gfae122.pdf?...
04.12.2024 23:22 — 👍 7 🔁 3 💬 1 📌 0

4/n unstained #UrinarySediment didn’t reveal much. Using Sternheimer-Malbin stain, we caught some cellular casts. Hard to be certain but they looked like renal tubular epithelial cells for the most part. Which would favor ATN as the primary culprit. But, we wanted more certainty…
04.12.2024 23:22 — 👍 5 🔁 1 💬 1 📌 0Nice case 🤩
06.12.2024 10:46 — 👍 0 🔁 0 💬 0 📌 0
Multiple nodules (slightly polypoid) protruding from nasal mucosa of a dog. The nodules are only slightly darker pink than the more normal mucosa.

Large, perhaps 200-micrometer-diameter, spherical organisns with a trilaminar wall and multiple smaller structures inside. It lies in the submucosa of the nose and is surrounded by macrophages, lymphocytes and plasma cells.

Spherical organisms of variable diameter but typically very large, with a thick capsule and grainy contents. These structures have thick walls, but only the largest has a trilaminar wall. The organisms are in the submucosa of the nose and are surrounded by macrophages, lymphocytes and plasma cells. Some macrophages contain hemosiderin.

Large spherical organisms of variable diameter with a thick capsule and granular contents. Some have a nucleus visible in the center. The largest is partially collapsed and has a trilaminar wall. The walls of smaller (developing) organisms only have one layer.
Here is a bipartisan #pathology case. It's relevent to DVMs and MDs. Lots of red (at least pink) and blue, too.
Rhinoscopy and nasal biopsy from a dog. What’s your diagnosis? It's a classic.
#vetpath #pathsky #Mesomycetozoea #pathology #respiratorypathology #endoscopy #rhinoscopy


Ooh, found a nice one to share from the ol' PathTwitter account. The buzzword for this diagnosis is a "jigsaw" pattern of nested cells. Thoughts?
#pathsky #dermpath #pathology

The peripheral smear can give a preview of what you'll find in the marrow. Here we see a circulating blast, a nucleated erythrocyte, and anisopoikilocytosis with frequent teardrop cells. What do you think the marrow might look like? 🤔
#hematopathology #hemepath #hematology #pathsky
Thanks 🦠
05.12.2024 09:57 — 👍 1 🔁 0 💬 0 📌 0The pigment is very similar to melanin due to the fineness of the grains, it does not seem to be hemosiderin. It could be due to tattooing. The crystals have a lateral and sometimes central reinforcement. I do not know them. I suggest history and determination of the pigment.😀 #foreignbodies
03.12.2024 11:41 — 👍 1 🔁 0 💬 1 📌 0


Papule on ear lob of a young woman.
Calcinose cutis?
#DermPath #PathSky
(So sad that I don’t see Pasqual and Dr Rosen on 🦋 Bsky yet)